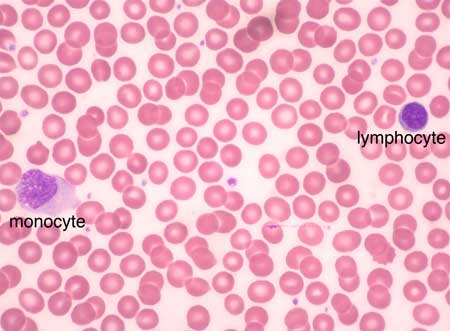
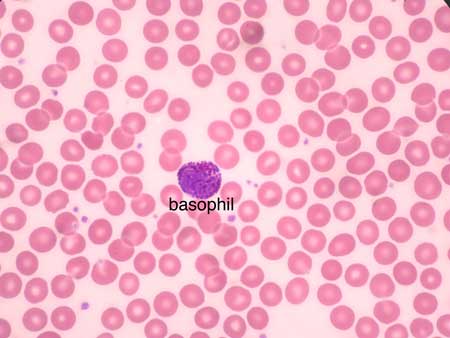

-
Histology Photomicrographs
Human Anatomy and Physiology (BIOL& 241L-242L)
Karen Hart, Peninsula College
Blood

Slide: Blood smear, human, Wright’s stain H6455
Microscope at 1000X
These images show erythrocytes (red blood cells), leukocytes (white blood cells) and platelets as they appear in a Wright's stained blood smear.
Platelets are pinched-off bits of cytoplasm (of a bone marrow cell called a megakaryocyte) enclosed in plasma membrane. Platelets contain various substances that contribute to blood clotting.
Erythrocytes are the most abundant blood cells (about 700 erythrocytes for every 1 leukocyte). Erythrocytes are smaller than leukocytes. An erythrocyte has no nucleus (it is ejected as the cell develops). Erythrocytes deliver O2 to the cells of the body. Hemoglobin molecules within erythrocytes bind O2 when erythrocytes pass through the high O2 environment of lung capillaries. Hemoglobin molecules release O2 when erythrocytes pass through the low O2 environment of capilliaries in the rest of the body.
The group of cells called leukocytes have important roles in defending the body against infection by microorganisms. Certain leukocytes (and cells derived from leukocytes) phagocytize and thereby recycle worn or dead body cells and cell fragments. Leukocytes perform most of their functions after they leave the blood and enter tissues. There are five types of leukoctyes each with a different appearance and function.
Neutrophils are the most abundant leukocyte (approximately 65% of the leukocytes). Neutrophils have a lobed nucleus and cytoplasm containing inconspicuous reddish-purple granules.
Lymphocytes (about 25% of leukocytes) are the smallest of the leukocytes, just a bit larger than erythrocytes. A lymphocyte has a large spherical nucleus and a thin rim of blue-gray cytoplasm.
Monocytes (about 6% of leykocytes) are the largest leukocytes and may show an irregular shape in blood smears. Monocytes typically have an indented nucleus and blue-gray cytoplasm.
Eosinphils (about 3% of leukocytes) have red granules in the cytoplasm and typically have a two-lobed nucleus.
Basophils (less than 1% of leukocytes) have prominent dark purple granules in the cytoplasm which partially obscure the lobed nucleus.
Slide: Blood smear, human, Wright’s stain H6455
Microscope at 1000X

Slide: Blood smear, human, Wright’s stain H6455
Microscope at 1000X
Slide: Blood smear, human, Wright’s stain H6455
Microscope at 1000X
Unless otherwise noted, contents © 2006-2026 Karen Hart